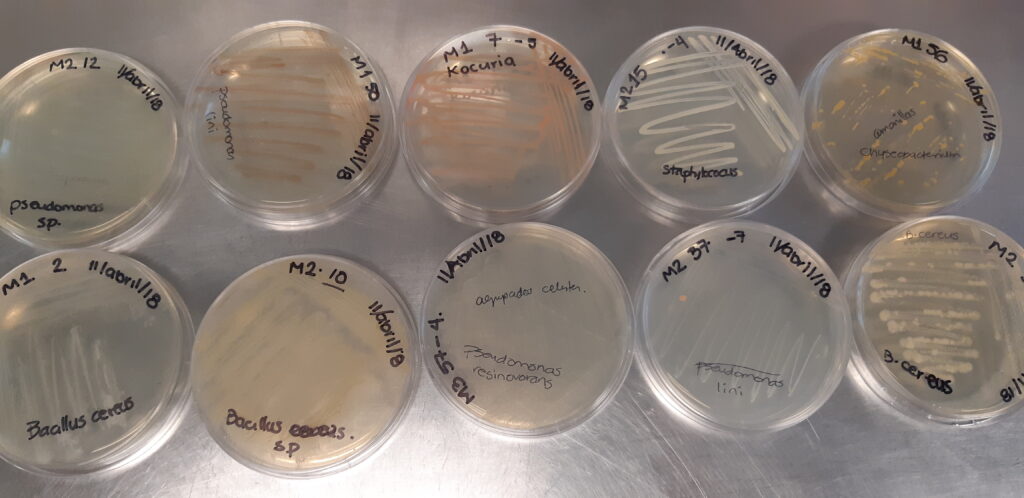
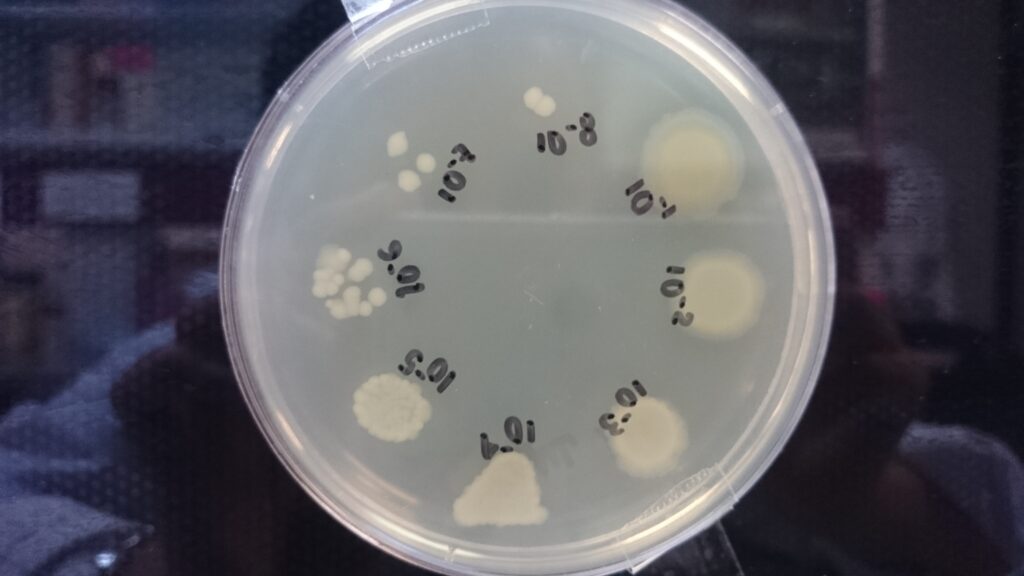

Este proyecto pretende estudiar la ecología microbiana de los diferentes nichos de la región, y saber cómo repercute en la salud del ser humano y especies animales.
Especialistas del Instituto Politécnico Nacional (IPN) realizan estudios orientados a conformar un mapa de las poblaciones microbianas que existen en el estado de Tamaulipas, con el propósito de evaluar sus características para detectar su aplicación en la actividad agrícola, en la biorremediación o establecer si algunos de ellos son resistentes a antibióticos y con base en los resultados obtenidos aportar datos a los sectores usuarios correspondientes.
La investigación se lleva a cabo en el Centro de Biotecnología Genómica (CBG) y es liderada por el doctor en Biología molecular e Ingeniería Genética, Virgilio Bocanegra García, quien mencionó que para clasificar las poblaciones microbianas toman muestras a partir de suelos agrícolas, aguas residuales y superficiales, alimentos frescos y procesados, animales silvestres y de producción ganadera, así como de origen clínico (proporcionadas por centros hospitalarios a través de colaboraciones).



El científico adscrito al Sistema Nacional de Investigadores (SNI) Nivel II comentó que en dicha tarea se han enfrentado a diversas situaciones. “Por ejemplo, hemos encontrado microorganismos que cubren los tres criterios de estudio, es decir, por su interacción benéfica con las plantas pueden ser útiles para la agricultura; son capaces de degradar contaminantes y se pueden usar para la biodegradación; sin embargo, también son patogénicos para el humano o los animales”, añadió.
El autor de alrededor de 70 artículos científicos sostuvo que este proyecto pretende estudiar la ecología microbiana de los diferentes nichos de la región, y saber cómo repercute en la salud del ser humano y especies animales. Mencionó que han encontrado en aguas residuales microorganismos resistentes a antibióticos, los cuales se presume que pueden provenir de las heces de los animales a los que se administran antibióticos con fines económicos para estimular su crecimiento y aumentar su masa muscular.
El doctor Bocanegra García refirió que el proyecto es muy complejo y de largo plazo, ya que tiene diversas aristas y por ello es necesario estudiar todos los nichos posibles para evaluar el perfil microbiano y la forma en que actúan para usar esa información como punto de partida para tomar decisiones encaminadas a procurar la salud de las personas, al considerar el uso de los fármacos más apropiados para evitar la multirresistencia.

En ese contexto, el investigador politécnico explicó que cuando un microorganismo drogorresistente entra en contacto con una bacteria inocua ésta puede adquirir esa característica, y se puede generar un problema cuando esa resistencia a los antibióticos se transmite a alguna bacteria patógena, la cual se vuelve más peligrosa y de esa manera se reducen las alternativas de tratamiento.
El integrante de las Redes de Biotecnología y de Salud del IPN mencionó que, además de reportar los resultados en publicaciones científicas, también los informan a los usuarios interesados.
“Si son de origen clínico el reporte se entrega a los médicos, los de tipo veterinario se proporcionan a los productores y los relacionados con el medio ambiente se hacen llegar a las instancias encargadas del manejo de los sistemas de agua y de riego”, indicó.
Fotos: IPN

